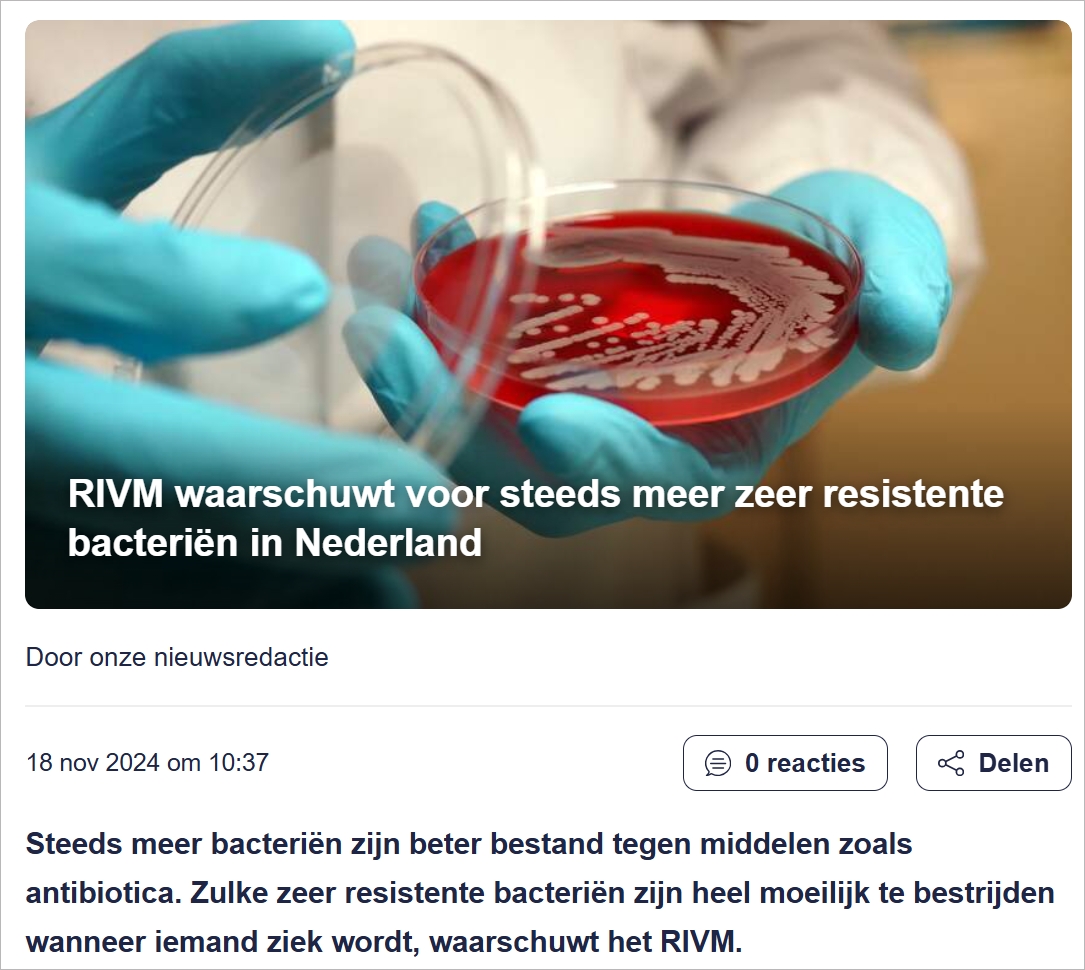
Image 50.jpg

据荷兰媒体报道,荷兰国家公共卫生与环境研究所RIVM警告称,越来越多的细菌对抗生素有更强的耐药性,当人们感染时,这类高度耐药细菌将变得非常难以治疗。
当频繁使用抗生素时,细菌最终会学会如何抵御这种攻击,这就是细菌对抗生素产生耐药性的原因。为了防止这种情况,荷兰医生非常不愿意开抗生素,因此荷兰的抗生素使用量远低于其他国家。
尽管如此,荷兰也有越来越多的高度耐药细菌。根据RIVM的数据,它们主要发生在出国住院的人群中,研究人员呼吁医生保持警惕。
根据这项研究,一组链球菌等对药物多西环素和四环素的耐药性越来越强,由于这些抗生素在医院中的使用频率较高,这可能是细菌产生耐药性的原因。
同样让研究人员担心的是肺炎克雷伯菌对抗生素美罗培南的耐药性增加,这种药物仅在患者有严重感染时使用,其他药物无效。
|
|
|
|
|
|
|
|
|
|
